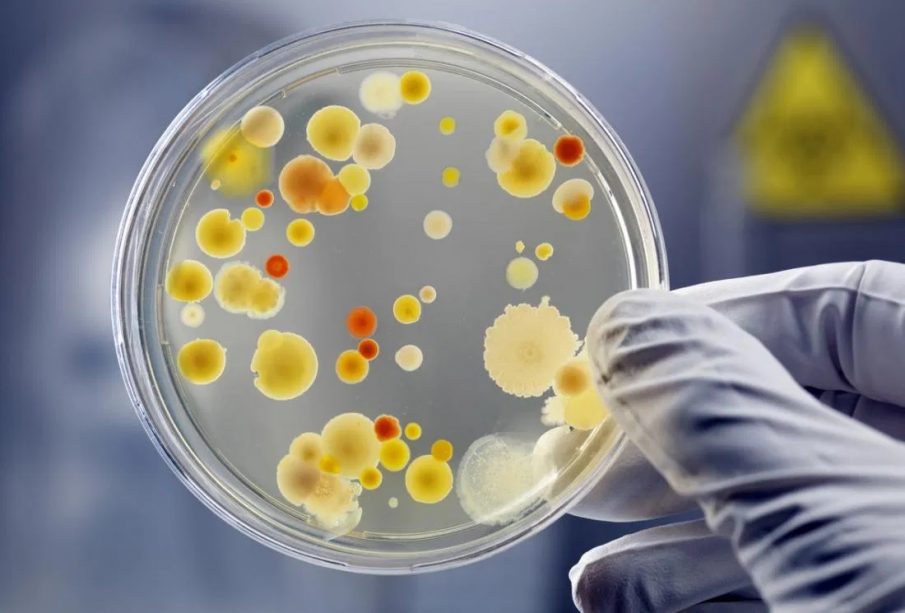

Skip to content


Historical Easter Eggs – Today in History
"Tell me a factand I'll learn. Tell me a truth, and I'll believe. But tell me a story, and it will live in my heart forever." – Steve Sabol, NFL Films